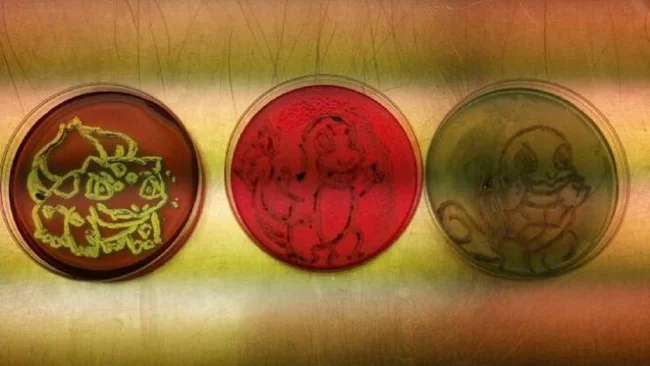

27 фотографий из жизни представителей разных профессий (28 фото)
Все профессии нужны, все профессии важны! В этой подборке собраны интересные снимки, которые, возможно, покажут вам рабочие будни профессионалов с новой и неожиданной стороны. 
1. Янез Брайкович и Томаш Марчински поделились снимками своих ног после велогонки 
2. "Рабочие руки на цементном заводе! Я котельщик, и это моя рука после рабочего дня в грязи и пыли. Выбирайте профессию с умом, дети" 
3. По этим дверным ручкам можно сразу понять, кто работает в здании 
4. "Моя рука после целого дня шлифовки стекловолокна" 
5. Персонал этого отеля умеет рассмешить 
6. Магазин перфекциониста 
7. Каждый день этот учитель из Ирана приходит к своему ученику в больницу 
8. Полицейские приготовили ужин для детей, когда их маму увезли в больницу 
9. Когда работники магазина не могут отказать покупателю в возврате товара 
"Кто додумался принять этот возврат? Эта вещь из летней коллекции 2000 года! Это было почти 17 лет назад! А у нас срок возврата - 45 дней! Если не знаете об этом, СПРАШИВАЙТЕ!"
10. "В мотеле мне подали завтрак за 15 долларов, в нем есть тостер и двухлитровая бутылка молока" 
11. "В ресторане подают французский луковый суп в настоящей луковице" 
12. Учитель математики пожелал детям счастливого Рождества 
13. Овощной оазис 
14. Лучший нянь 
15. "Заскучал на работе, решил порисовать бактериями"
16. Чтобы ни один волосок не попал в заказ 
17. У ночного кассира слишком много свободного времени 
18. Официантка помогла посетителю со стаканом 
19. Шлем настоящего героя 
20. Японские железнодорожники построили эти специальные туннели, чтобы помочь черепахам безопасно пересечь пути 
21. Эта учительница спасла котенка 
22. "Каждый год библиотекарь моей школы наряжается в костюм жницы, чтобы собрать книги" 
23. "Слышал, вы любите порядок во всем?" 
24. "При бронировании номера я попросил, чтобы на моей подушке была фотография Николаса Кейджа. Меня услышали" 
25. 
26. 
27. "Проработав официанткой 40 с лишним часов в неделю, я наконец-то заработала достаточно денег, чтобы оплатить семестр учебы в колледже" 





